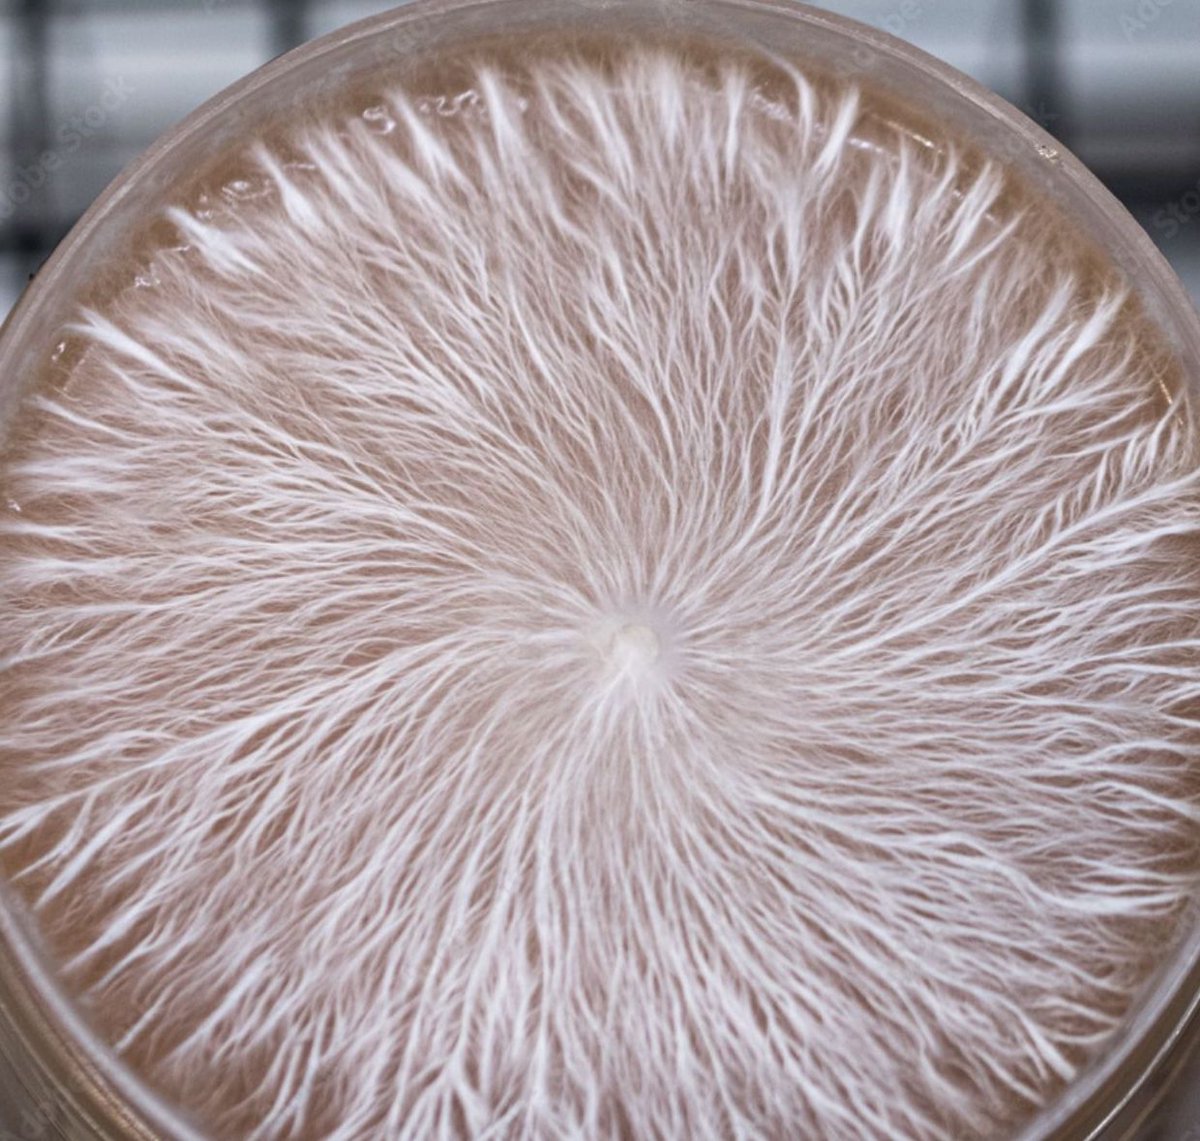
#Fungi, in general, are considered to be carbon dioxide (CO2) neutral or even slightly carbon negative, meaning they have the potential to sequester more carbon than they release during their life cycle.

Kidemis
@kidemis_suisse
🧬 Mycelium🧬 protein for:
🐟 fish
🦀 crustacean 🦐 🍤🐙🦑
🦐🐟🦀 other aquaculture 🍤🐠🦀🐙🦑🦂🐡🐟🦐🦠
ID: 1597316064983089155
http://kidemis.com/ 28-11-2022 19:47:13
606 Tweet
122 Followers
259 Following













The biggest names in the agri-food ecosystem have confirmed to attend @APACAgriFood. Will you join them? The summit connects influential stakeholders addressing food security, resilience and nutrition across every step of the value chain. Join them: lnkd.in/gQMMKX8